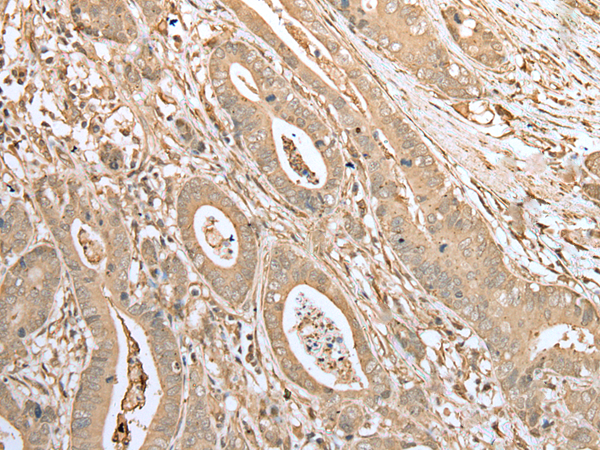

|
Background: |
Adipogenesis, the process of transforming pre-adipocytes into mature fat cells, is of particular interest due to the role adipocytes play in obesity and type II diabetes. Adipocytes have been shown to affect a variety of functions, including hemostasis, angiogenesis and energy balance, by secreting hormones and bioactive peptides. The FNDC3B protein, also designated FAD104 (factor for adipocyte differentiation 104) or HCV NS5A-binding protein 37, is expressed during early adipogenesis. Belonging to the FNDC3 family of proteins, FNDC3B is a 1,204 amino acid protein that contains nine fibronectin type-III domains. FNDC3B-deficient mice die within one day of birth, suggesting that FNDC3B is crucial for postpartum survival. Mouse embryonic fibroblasts (MEFs) with loss of FNDC3B function displayed a reduction in stress fiber formation, indicating a role for FNDC3B in cell proliferation, adhesion, spreading and migration. |
|
Applications: |
ELISA, IHC |
|
Name of antibody: |
FNDC3B |
|
Immunogen: |
Full length fusion protein |
|
Full name: |
fibronectin type III domain containing 3B |
|
Synonyms: |
FAD104; PRO4979; YVTM2421 |
|
SwissProt: |
Q53EP0 |
|
ELISA Recommended dilution: |
5000-10000 |
|
IHC positive control: |
Human liver cancer and human gastric cancer |
|
IHC Recommend dilution: |
30-150 |
購(gòu)物車
幫助
021-54845833/15800441009
